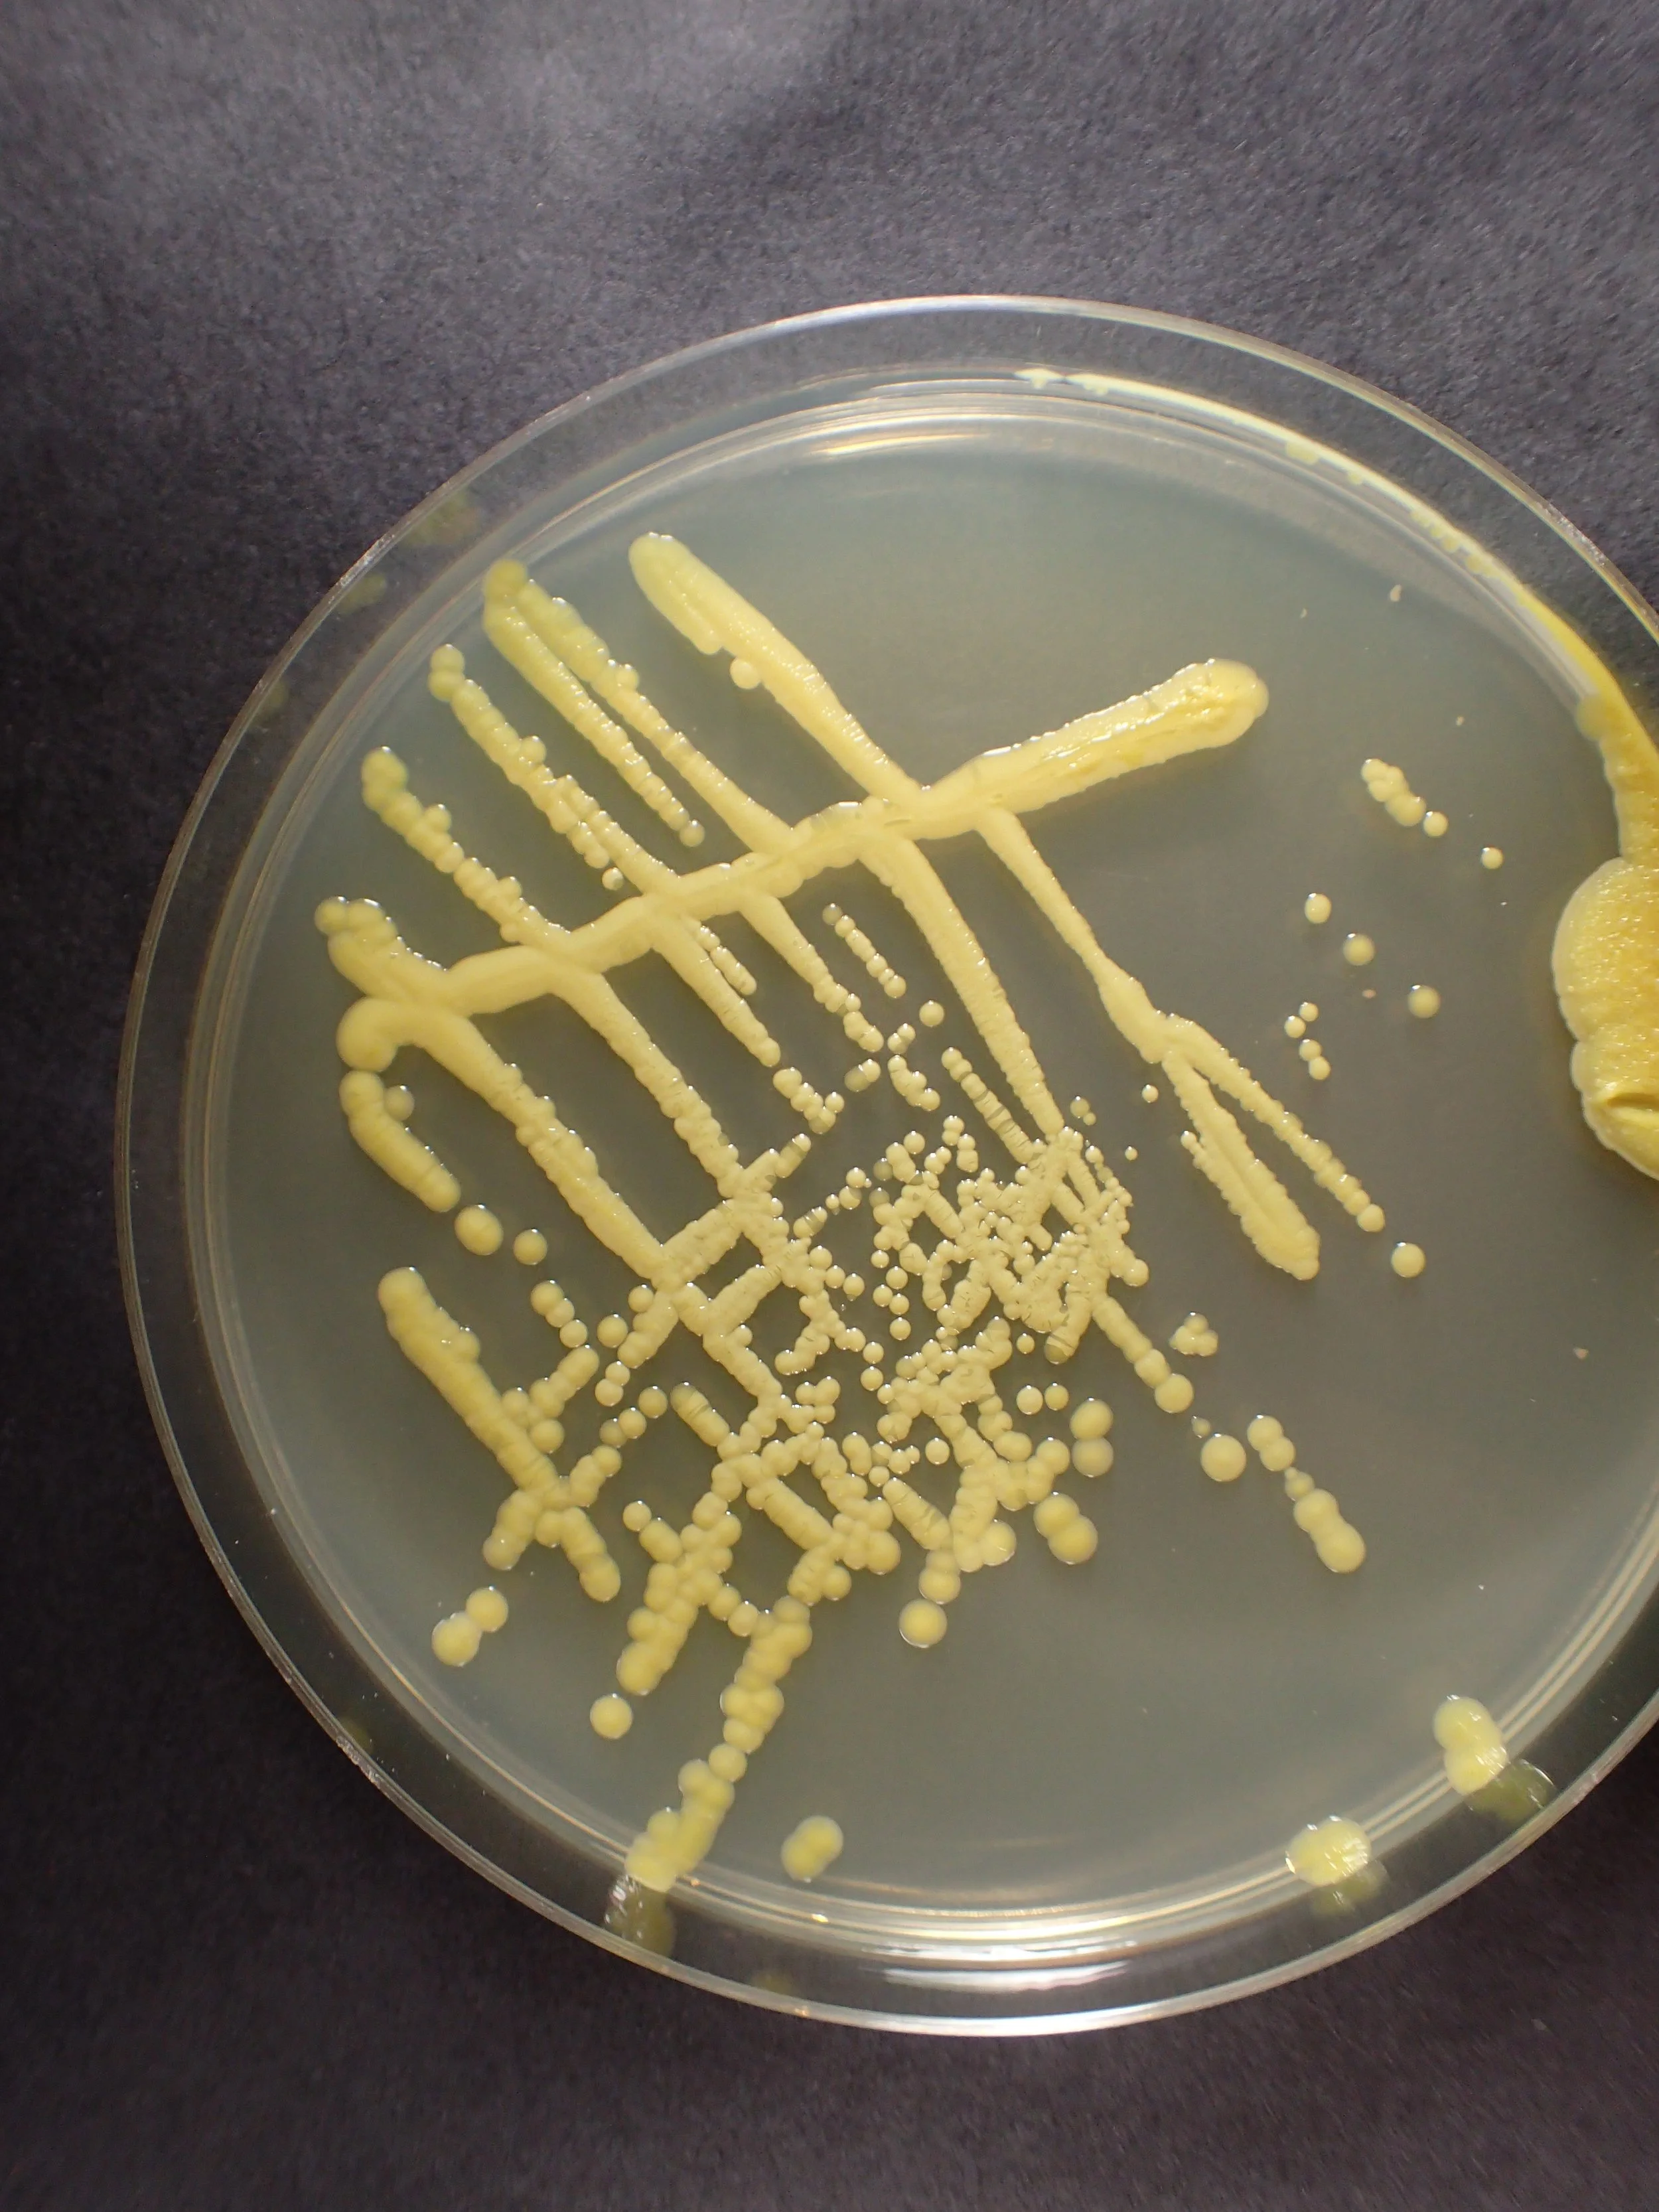
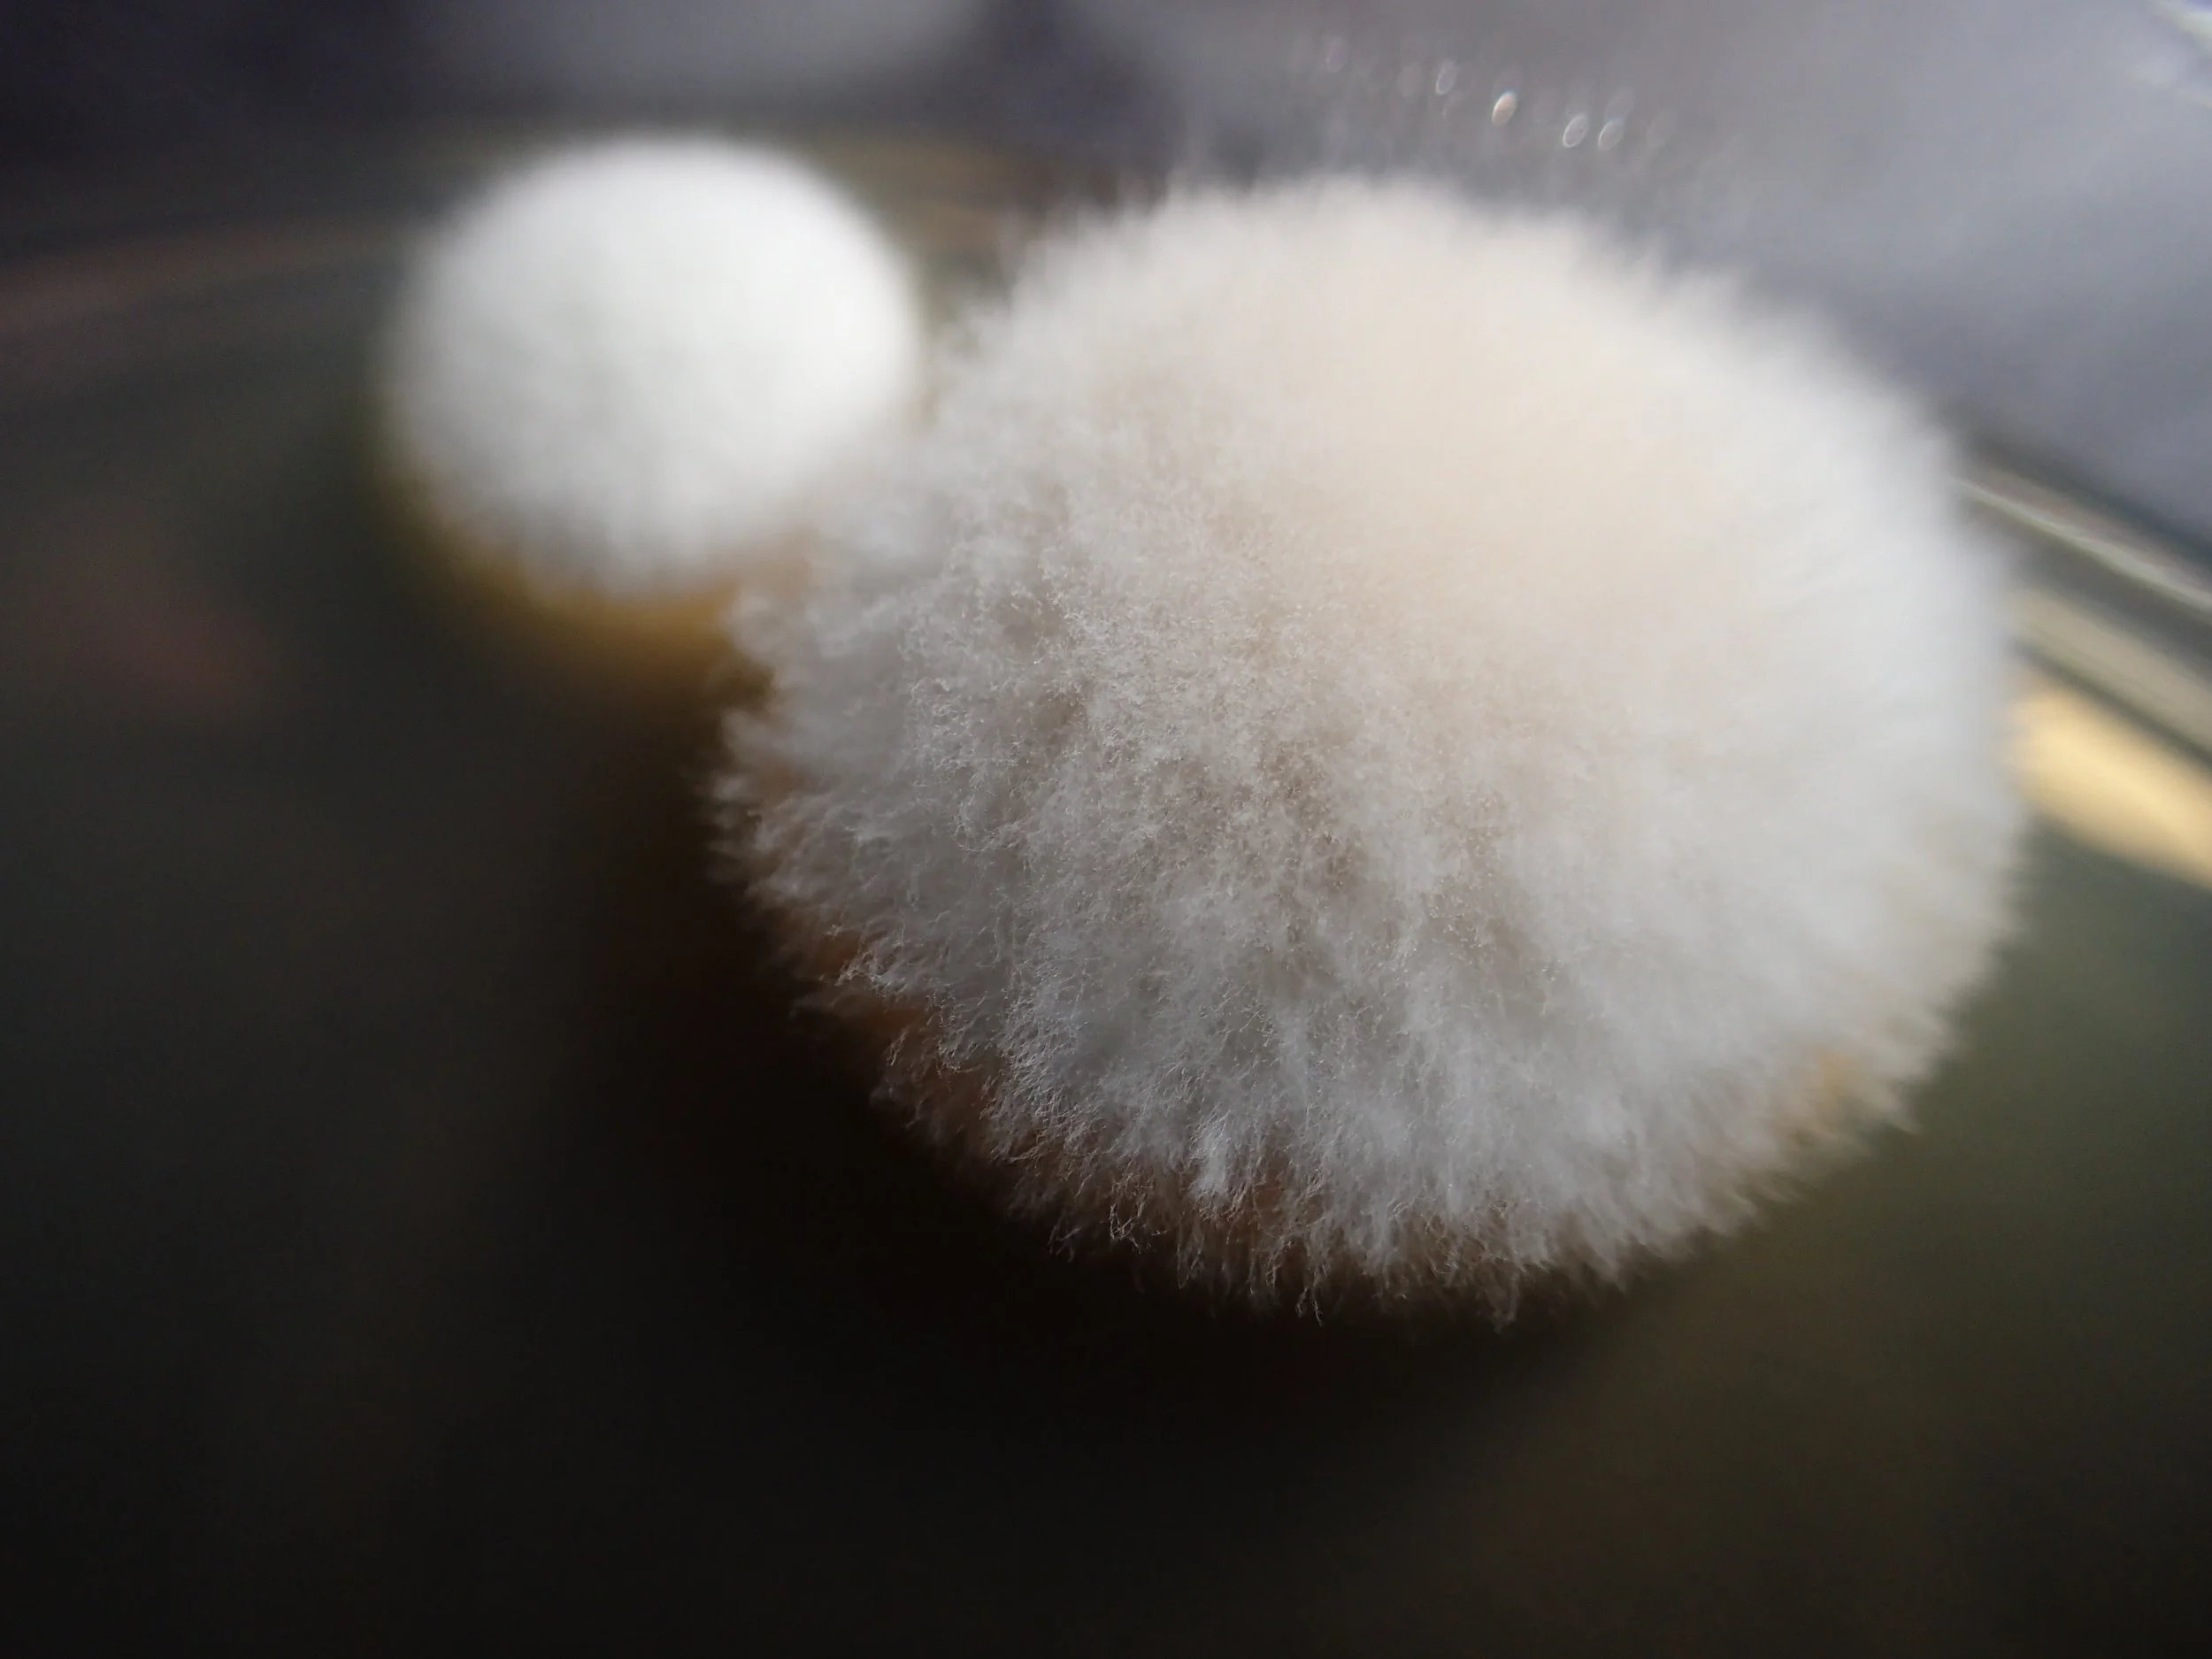
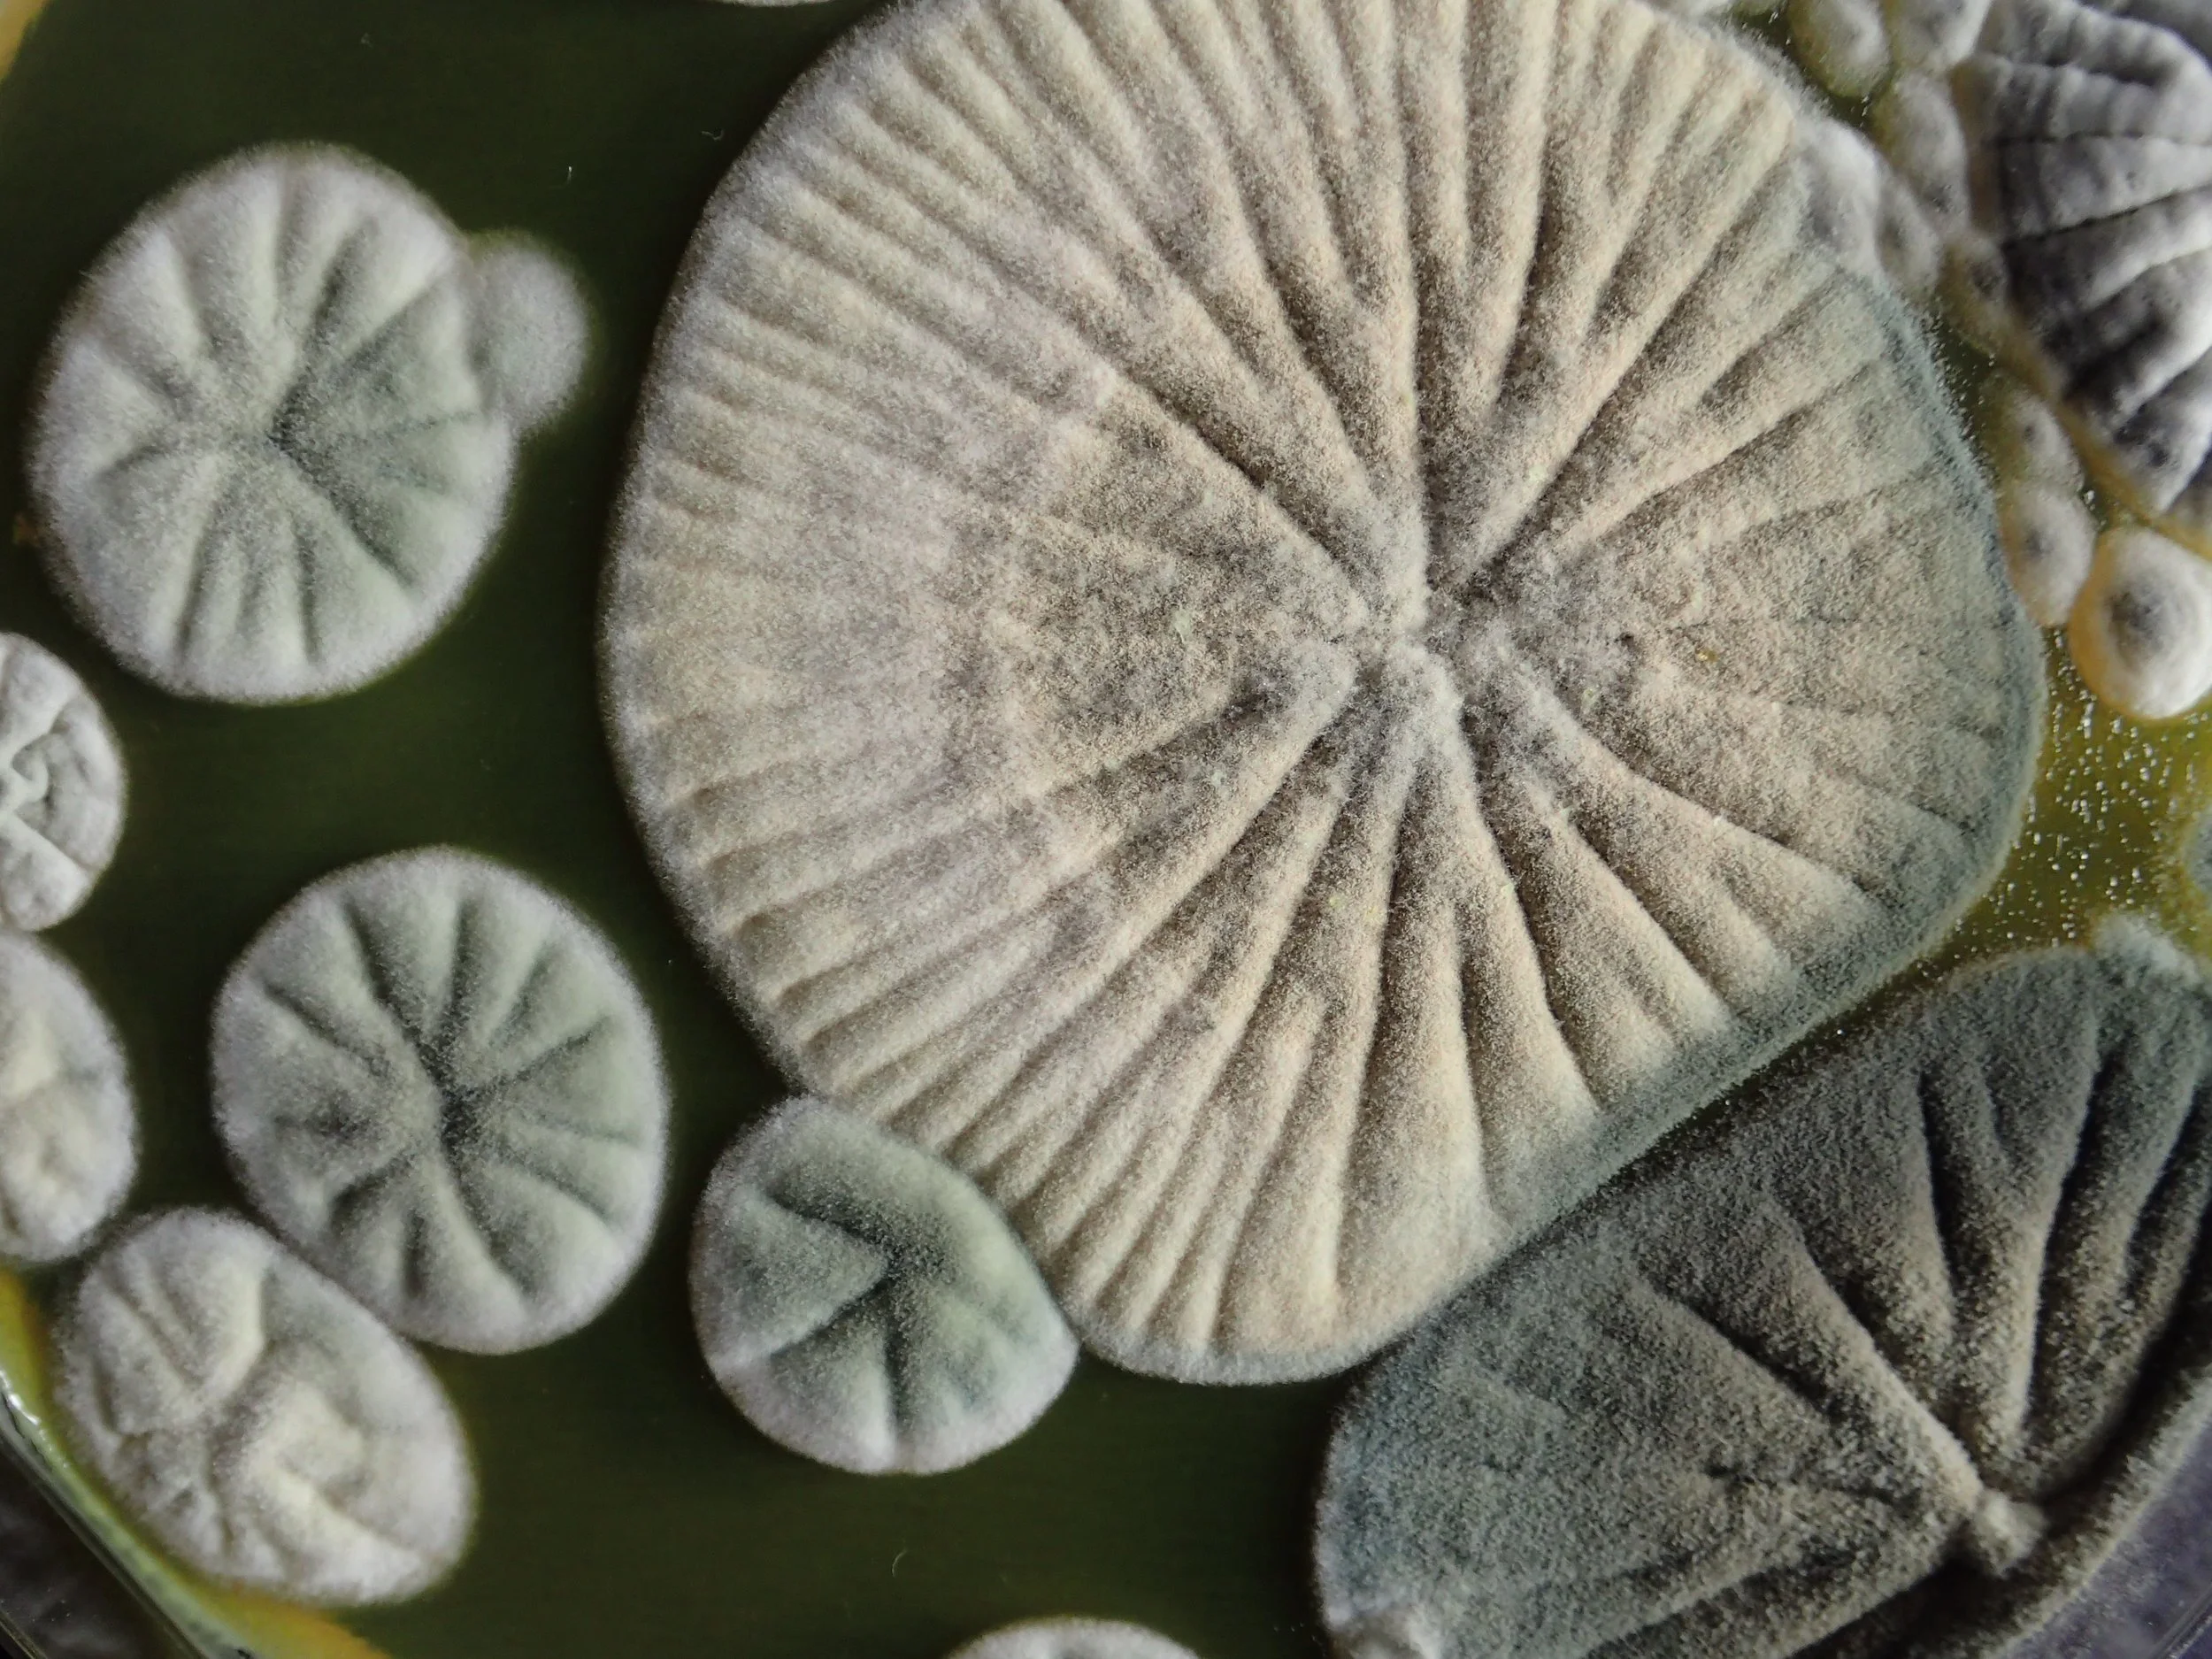

Microbial Life
Contaminants and lab accidents. Finding beauty and diverse life forms in failed experiments.
Things often go wrong in the lab. One of the most common of such 'lab accidents' is contamination. All of the sudden a new organism is growing on your agar plates, which should only carry yeast or E. coli. Yet, there is a fascinating variety in form and color of these little critters out there. From bright shiny bacterial colonies, to the most cute and fluffy fungi. The diversity is endless. Instead of directly dumping such contaminated plates in the garbage, we document each of these little lost travelers that live on and around us. Enjoy the beauty of these fascinating accidental encounters.